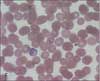

- Clinical Technology
- Adult Immunization
- Hepatology
- Pediatric Immunization
- Screening
- Psychiatry
- Allergy
- Women's Health
- Cardiology
- Pediatrics
- Dermatology
- Endocrinology
- Pain Management
- Gastroenterology
- Infectious Disease
- Obesity Medicine
- Rheumatology
- Nephrology
- Neurology
- Pulmonology
Woman With Purpura Fulminans
The patient is severely ill. Temperature is 39°C (102.2°F). Shortly after admission, she requires intubation with ventilatory support. Hypotension, acrocyanosis, and an ecchymotic rash consistent with purpura fulminans (A) rapidly develop.

The patient is severely ill. Temperature is 39°C (102.2°F). Shortly after admission, she requires intubation with ventilatory support. Hypotension, acrocyanosis, and an ecchymotic rash consistent with purpura fulminans (A) rapidly develop.

Physical examination reveals an abrasion in the second web space of the left hand (B), which resulted from a dog bite at work 72 hours earlier. The white blood cell count is 1000/μL; platelet count, 8000/μL; hemoglobin level, 8.9 g/dL; and blood urea nitrogen and creatinine levels are 22 mg/dL and 3.3 mg/dL, respectively. Arterial blood gases are representative of a compensated anion gap metabolic acidemia (with a pH of 7.20).
Blood cultures are obtained. Empiric therapy with vancomycin, ceftriaxone, and penicillin is initiated. A buffy coat specimen demonstrates fusiform-like gramnegative bacilli (C). Skin biopsy specimen reveals smallvessel fibrin-platelet thrombi without organisms.
The patient’s condition deteriorates, and she becomes unresponsive. A CT scan of the head shows findings consistent with subarachnoid and intraventricular hemorrhages. She dies within 48 hours.
What caused this patient’s rapid deterioration?
(answer on next page)
Answer: Capnocytophaga canimorsus sepsis
Blood cultures grew Capnocytophaga canimorsus, a microaerophilic, gram-negative rod that is part of the normal oral flora of dogs, cats, and livestock. However, this opportunistic pathogen is associated with multiorgan failure in humans; it can cause severe infection in persons who have impaired immunity, most commonly as a result of alcoholism or corticosteroid use, and in persons who are asplenic.

C canimorsus may be rapidly identified by microscopic examination of a Wright-stained buffy coat. The bacillus is thin with curved, tapered ends; it may be found intracellularly in the buffy coat. The smear is more likely to be positive in asplenic persons, with a reported sensitivity of 90%.1
Blood cultures may become positive within 6 days or in as long as 14 days. This organism replicates on chocolate agar enriched with 5% carbon dioxide.2 Some laboratories are unable to definitively identify C canimorsus and report the bacterium as either a “gram-negative rod” or a “fastidious gram-negative species.” A 3-decade summary of C canimorsus cultures revealed a 32% sensitivity for specific identification of this organism.3
C canimorsus is sensitive to penicillin, third-generation cephalosporins, quinolones, clindamycin, erythromycin, and vancomycin. However, infection with C canimorsus is associated with 28% mortality.1,4

Because this patient did not appear to have the typical risk factors associated with a fulminant course, what might have accounted for her death? The absence of normal splenic enhancement on an abdominal CT scan was consistent with a splenic infarction (Figure). The scan also showed bilateral perinephric fluid collections. At autopsy, the patient’s spleen was boggy with extensive areas of the splenic parenchyma that demonstrated loss of histological architecture. Even though a splenic infarction could not be detected in microscopic sections, it was presumed that the extensive splenic edema present during sepsis was indicative of impaired splenic function.
References:
REFERENCES:
1
. Kullberg BJ, Westendorp RG, van ‘t Wout JW, Meinders AE. Purpura fulminans and symmetrical peripheral gangrene caused by
Capnocytophaga canimorsus
(formerly DF-2) septicemia-a complication of dog bite.
Medicine (Baltimore)
. 1991;70:287-292.
2
. Newton L. An unusual case of septicaemia.
N Z J Med Lab Sci.
2006;60:59-60.
3
. Janda JM, Graves MH, Lindquist D, Probert WS. Diagnosing Capnocytophaga canimorsus infections.
Emerg Infect Dis.
2006;12:340-342.
4
. Mirza I, Wolk J, Toth L, et al. Waterhouse-Friderichsen syndrome secondary to Capnocytophaga canimorsus septicemia and demonstration of bacteremia by peripheral blood smear.
Arch Pathol Lab Med.
2000;124:859-863.
